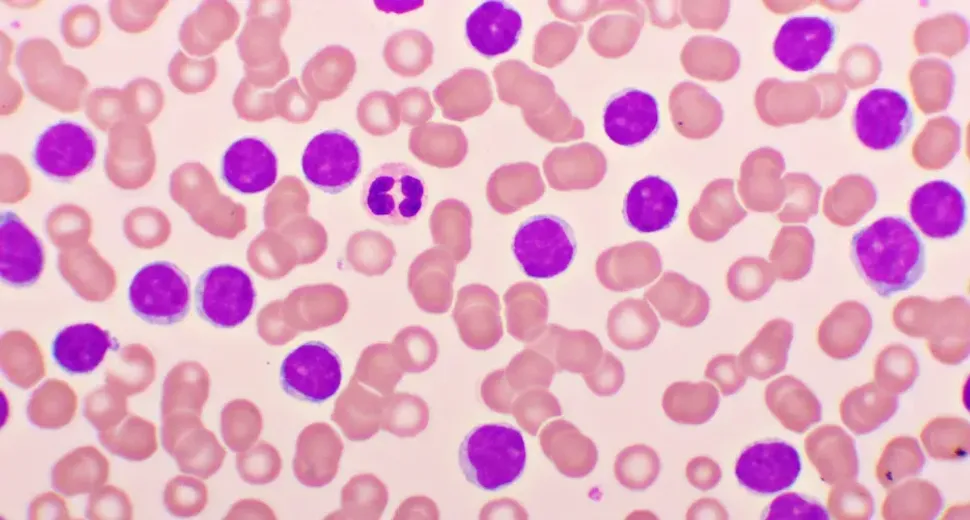
Discussing Unmet Clinical Needs in CLL with Silvia Deaglio, MD, PhD image

Discussing Unmet Clinical Needs in CLL with Silvia Deaglio, MD, PhD
Medical geneticist Silvia Deaglio, MD, PhD, from the University of Turin in Italy, shared insight with HealthTree at the EHA 2024 conference about addressing unmet clinical needs for two CLL patient groups: those with double-resistant disease and those with Richter transformation. Watch Dr. Deaglio’s interview or read the summary below.
Double-Resistant CLL
The first group of CLL patients who represent an unmet clinical need are those double-resistant to both BTK inhibitors and BCL-2 inhibitors. Dr. Deaglio stated that, at the moment, it is unclear which treatment is best for this patient group.
The path forward likely involves patients participating in clinical trials. Click here for more information about treatment options available for double-resistant CLL.
Richter Transformation
The second group involves patients experiencing Richter transformation. This is a serious complication where the typically slow-growing CLL changes into a more aggressive form of cancer known as diffuse large B-cell lymphoma (DLBCL). Each year, up to 1% of CLL patients face this transformation, which is particularly challenging because this form of cancer often does not respond well to standard lymphoma therapies.
Research into the genetic and functional changes in CLL cells during Richter transformation has shed some light on potential pathways for intervention. Studies have shown that during the transformation, CLL cells undergo significant changes in metabolizing nutrients and regulating cell death. They become more efficient at consuming glucose and enhancing their mitochondrial activity, which supports faster growth and survival. Currently, no approved medicines specifically targeting these metabolic changes in CLL exist, but research is ongoing.
The Path Forward
Dr. Deaglio stressed the importance of researchers understanding the biological changes in CLL cells that lead to double-resistant disease and Richter transformation. Doing so will help accelerate the development of treatment options for these patient groups.
If you have double-resistant CLL or have experienced Richter transformation, consult with your CLL specialist about potential clinical trials you can join to help improve your outcome.
Interested in Joining a Clinical Trial? Search HealthTree’s Clinical Trial Finder
If you would like to review your eligibility for joining a clinical trial, please click the button below to access HealthTree’s clinical trial finder.
Browse CLL & Richter Transformation Clinical Trials
Medical geneticist Silvia Deaglio, MD, PhD, from the University of Turin in Italy, shared insight with HealthTree at the EHA 2024 conference about addressing unmet clinical needs for two CLL patient groups: those with double-resistant disease and those with Richter transformation. Watch Dr. Deaglio’s interview or read the summary below.
Double-Resistant CLL
The first group of CLL patients who represent an unmet clinical need are those double-resistant to both BTK inhibitors and BCL-2 inhibitors. Dr. Deaglio stated that, at the moment, it is unclear which treatment is best for this patient group.
The path forward likely involves patients participating in clinical trials. Click here for more information about treatment options available for double-resistant CLL.
Richter Transformation
The second group involves patients experiencing Richter transformation. This is a serious complication where the typically slow-growing CLL changes into a more aggressive form of cancer known as diffuse large B-cell lymphoma (DLBCL). Each year, up to 1% of CLL patients face this transformation, which is particularly challenging because this form of cancer often does not respond well to standard lymphoma therapies.
Research into the genetic and functional changes in CLL cells during Richter transformation has shed some light on potential pathways for intervention. Studies have shown that during the transformation, CLL cells undergo significant changes in metabolizing nutrients and regulating cell death. They become more efficient at consuming glucose and enhancing their mitochondrial activity, which supports faster growth and survival. Currently, no approved medicines specifically targeting these metabolic changes in CLL exist, but research is ongoing.
The Path Forward
Dr. Deaglio stressed the importance of researchers understanding the biological changes in CLL cells that lead to double-resistant disease and Richter transformation. Doing so will help accelerate the development of treatment options for these patient groups.
If you have double-resistant CLL or have experienced Richter transformation, consult with your CLL specialist about potential clinical trials you can join to help improve your outcome.
Interested in Joining a Clinical Trial? Search HealthTree’s Clinical Trial Finder
If you would like to review your eligibility for joining a clinical trial, please click the button below to access HealthTree’s clinical trial finder.

about the author
Megan Heaps
Megan joined HealthTree in 2022. She enjoys helping patients and their care partners understand the various aspects of the cancer. This understanding enables them to better advocate for themselves and improve their treatment outcomes.
More on Conferences
Trending Articles
Get the Latest Chronic Lymphocytic Leukemia Updates, Delivered to You.
By subscribing to the HealthTree newsletter, you'll receive the latest research, treatment updates, and expert insights to help you navigate your health.
Together we care.
Together we cure.








